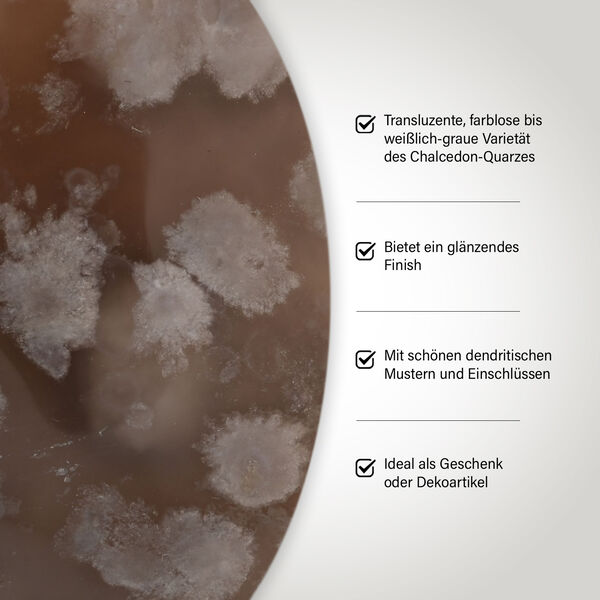
Gem Crystal Kollektion - Dendritischer wei&szlig;er Achat - M, ca. 2500 cts. image number 3

|
46% Rabatt
80,99 €
Inkl. MwSt.
Für diesen Einkauf erhalten Sie 80 Punkte. Mehr erfahren.